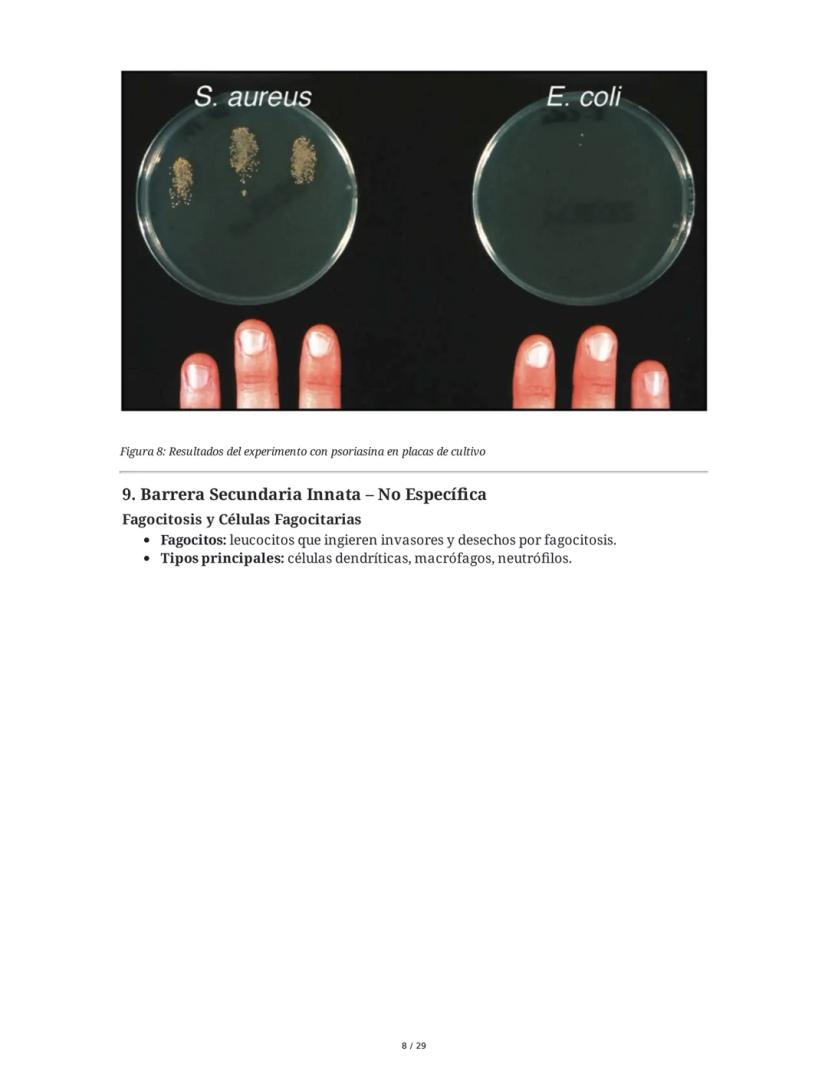
Page 8

El sistema inmunitario es nuestro escudo protector contra gérmenes y... Mostrar más
Inscríbete para ver los apuntes¡Es gratis!
Acceso a todos los documentos
Mejora tus notas
Únete a millones de estudiantes
Asignaturas
Triangle Congruence and Similarity Theorems
Triangle Properties and Classification
Linear Equations and Graphs
Geometric Angle Relationships
Trigonometric Functions and Identities
Equation Solving Techniques
Circle Geometry Fundamentals
Division Operations and Methods
Basic Differentiation Rules
Exponent and Logarithm Properties
Mostrar todos los temas
Human Organ Systems
Reproductive Cell Cycles
Biological Sciences Subdisciplines
Cellular Energy Metabolism
Autotrophic Energy Processes
Inheritance Patterns and Principles
Biomolecular Structure and Organization
Cell Cycle and Division Mechanics
Cellular Organization and Development
Biological Structural Organization
Mostrar todos los temas
Chemical Sciences and Applications
Atomic Structure and Composition
Molecular Electron Structure Representation
Atomic Electron Behavior
Matter Properties and Water
Mole Concept and Calculations
Gas Laws and Behavior
Periodic Table Organization
Chemical Thermodynamics Fundamentals
Chemical Bond Types and Properties
Mostrar todos los temas
European Renaissance and Enlightenment
European Cultural Movements 800-1920
American Revolution Era 1763-1797
American Civil War 1861-1865
Global Imperial Systems
Mongol and Chinese Dynasties
U.S. Presidents and World Leaders
Historical Sources and Documentation
World Wars Era and Impact
World Religious Systems
Mostrar todos los temas
Classic and Contemporary Novels
Literary Character Analysis
Rhetorical Theory and Practice
Classic Literary Narratives
Reading Analysis and Interpretation
Narrative Structure and Techniques
English Language Components
Influential English-Language Authors
Basic Sentence Structure
Narrative Voice and Perspective
Mostrar todos los temas
103
•
Actualizado Mar 31, 2026
•
Martín
@zz0mb1t3
El sistema inmunitario es nuestro escudo protector contra gérmenes y... Mostrar más






























¿Alguna vez te has preguntado cómo tu cuerpo lucha contra los resfriados? Todo comienza con los microorganismos, seres diminutos visibles solo con microscopio. Las bacterias son celulares con su propio metabolismo, mientras que los virus son acelulares y necesitan células huésped para reproducirse.
Las bacterias tienen formas variadas como cocos (esferas), bacilos (bastones) y espiroquetas (espirales). ¡Se reproducen súper rápido! En solo 20 minutos pueden duplicarse mediante fisión binaria. Los virus, por su parte, pueden seguir ciclos líticos (reproducción activa) o lisogénicos (permanecen latentes).
Tu sistema inmunitario es un equipo complejo de células, tejidos y órganos que trabajan juntos para protegerte. Sus principales tareas son detectar invasores, eliminarlos, prevenir que vuelvan a infectarte y eliminar células defectuosas como las cancerosas.
¡Dato curioso! Aunque muchos microorganismos pueden causarnos enfermedades, la mayoría son inofensivos e incluso algunos son beneficiosos para nuestra salud, como las bacterias intestinales que nos ayudan a digerir alimentos.

Tu cuerpo es muy inteligente para identificar intrusos. El sistema inmunitario detecta antígenos (moléculas extrañas) en la superficie de bacterias y virus. Cuando encuentra estos antígenos, produce anticuerpos específicos para combatirlos.
Imagina que una bacteria intenta invadir tu cuerpo. Tu sistema inmunitario identifica proteínas en su membrana como "extrañas". De forma similar, cuando un virus como el coronavirus intenta infectarte, las proteínas de su superficie (como las proteínas S, E y M) son reconocidas como invasoras.
Es como si cada intruso llevara una etiqueta que dice "¡No pertenezco aquí!" y tu sistema inmunitario está constantemente vigilando para detectar estas etiquetas.
¡Importante! La especificidad es la clave del sistema inmunitario: los anticuerpos se ajustan exactamente al antígeno como una llave a su cerradura. Esta precisión permite atacar solo a los invasores sin dañar tus propias células.

Tu sistema inmunitario tiene su propia geografía, con órganos especializados distribuidos por todo el cuerpo. Se organiza en dos tipos principales: órganos linfoides primarios (donde las células inmunitarias nacen y maduran) y secundarios (donde actúan).
La médula ósea es la fábrica principal donde se producen todas las células sanguíneas, incluidas las células inmunitarias. El timo es como una escuela donde las células T aprenden a distinguir lo propio de lo extraño. Los ganglios linfáticos, las amígdalas y el bazo funcionan como puestos de control donde se inician las respuestas inmunitarias.
El proceso de selección clonal es fascinante: tu cuerpo genera millones de células con receptores diferentes, elimina las que podrían atacar tus propias células, y cuando encuentra un invasor, selecciona y multiplica las células específicas para combatirlo.
¡Increíble! Tu médula ósea produce unos 100 mil millones de células inmunitarias nuevas cada día. ¡Es como si toda la población de México se renovara diariamente dentro de tu cuerpo!

Tu cuerpo tiene dos equipos de defensa: la inmunidad innata (rápida pero general) y la inmunidad adaptativa (lenta pero específica y con memoria).
La inmunidad innata es como los guardias de seguridad de un edificio. Responde inmediatamente y de la misma manera ante cualquier intruso. Incluye:
La inmunidad adaptativa es como un equipo de investigadores especializados. Tarda días en activarse pero genera una respuesta específica y mejora con cada exposición. Sus componentes principales son:
¡Dato importante! La inmunidad adaptativa es la razón por la que las vacunas funcionan y por qué generalmente no te da la misma enfermedad dos veces con la misma intensidad.

¿Te has preguntado por qué algunas enfermedades solo las sufres una vez? La respuesta está en cómo tu sistema inmunitario aprende y recuerda.
La primera vez que te expones a un microbio (respuesta primaria), tu cuerpo tarda entre 10 y 20 días en desarrollar una defensa completa. Es como aprender a jugar un nuevo videojuego: al principio eres lento y cometes errores.
Pero lo interesante ocurre en la segunda exposición (respuesta secundaria). Tu cuerpo reacciona mucho más rápido y con mayor fuerza gracias a las células de memoria que guardaron información del primer encuentro. Es como volver a jugar ese videojuego después de haberlo practicado: ahora eres un experto.
El gráfico de respuesta inmunitaria muestra claramente cómo la segunda vez la reacción es más rápida y potente que la primera, ¡tu cuerpo se vuelve un profesional combatiendo ese invasor específico!
¡Asombroso! Las células de memoria pueden vivir durante décadas, proporcionándote protección a largo plazo contra patógenos que ya has enfrentado antes.

Tu primera línea de defensa son las barreras físicas y químicas que impiden la entrada de invasores. ¡Es como tener un muro alrededor de tu castillo!
La piel es una increíble fortaleza: sus células apretadas bloquean la entrada de microbios, mientras que el sudor y el sebo contienen sustancias antimicrobianas como la psoriasina que mata bacterias como E. coli. Por eso los médicos insisten tanto en lavarse las manos: ¡para eliminar los invasores antes de que encuentren una entrada!
Las membranas mucosas recubren las aberturas de tu cuerpo como la nariz, boca y tracto digestivo. Producen moco que atrapa microbios, tienen cilios (pequeños pelitos) que los barren hacia afuera, y contienen enzimas que los destruyen. ¡Tu estómago incluso usa ácido para disolver invasores!
¡Experimento real! Científicos demostraron el poder de la psoriasina en nuestra piel poniendo E. coli y S. aureus en dedos humanos. Mientras S. aureus sobrevivió y creció en placas de cultivo, E. coli fue eliminada por la psoriasina. ¡Tu piel tiene su propio antibiótico natural!

Si algún invasor logra atravesar tus barreras primarias, se encontrará con un ejército de células especializadas listas para "comérselo". Este proceso se llama fagocitosis y es como tener patrullas policiales recorriendo tu cuerpo.
Los principales tipos de células fagocitarias son:
Estas células usan seudópodos (falsos pies) para rodear al invasor, lo encierran en una burbuja llamada fagosoma, y luego lo destruyen con enzimas digestivas de los lisosomas.
¡Increíble! Un solo neutrófilo puede fagocitar hasta 20 bacterias antes de morir. Con millones de estas células circulando en tu sangre, ¡tienes un ejército impresionante!

Las células NK (Natural Killer) son los francotiradores de tu sistema inmunitario. No necesitan reconocimiento previo para actuar - atacan células infectadas por virus y células cancerosas de inmediato.
¿Cómo distinguen las células buenas de las malas? Las células sanas muestran proteínas llamadas MHC-I que funcionan como un "carnet de identidad". Si una célula no muestra este carnet (como ocurre con células infectadas o cancerosas), las NK la eliminan mediante la liberación de perforinas y granzimas que provocan su muerte programada.
Cuando hay daño tisular o infección, se desencadena la respuesta inflamatoria. Es una reacción compleja que causa los cuatro signos clásicos de la inflamación:
La inflamación atrae a más células defensoras al sitio y acelera la curación. La fiebre también ayuda, pues el aumento de temperatura dificulta la reproducción de muchas bacterias.
¡Dato útil! Aunque la inflamación puede ser molesta, es un signo de que tu sistema inmunitario está trabajando. Sin embargo, una inflamación crónica puede ser perjudicial y está relacionada con muchas enfermedades.

La inmunidad adaptativa es como tener un equipo SWAT entrenado específicamente para cada tipo de invasor. Sus principales agentes son los linfocitos B y T, que se desarrollan en la médula ósea y el timo respectivamente.
Los linfocitos T son cruciales para la inmunidad celular. Hay varios tipos:
El proceso comienza cuando un fagocito presenta fragmentos del patógeno (antígenos) a los linfocitos T. Estos se activan, se multiplican y algunos se convierten en células de memoria. Los T citotóxicos liberan sustancias que destruyen las células infectadas mediante apoptosis (muerte celular programada).
Para que este sistema funcione, es necesaria la cooperación entre distintos tipos de células. Es como una operación militar donde cada unidad tiene su función específica.
¡Fascinante! Los receptores de los linfocitos T son tan diversos que pueden reconocer prácticamente cualquier molécula extraña. Tu cuerpo puede generar hasta 10^18 (un trillón) de receptores diferentes, ¡más que el número de átomos en la Tierra!

La inmunidad humoral es tu sistema de defensa basado en anticuerpos, unas proteínas especializadas que circulan en fluidos corporales y "marcan" invasores para su destrucción.
Los linfocitos B son los protagonistas de esta historia. Cuando un linfocito B encuentra un antígeno que encaja con su receptor:
Los anticuerpos actúan de varias formas:
¡Dato asombroso! Una sola célula plasmática puede producir más de 2,000 anticuerpos por segundo durante sus 4-5 días de vida. Con millones de estas células trabajando a la vez, ¡tu cuerpo fabrica un arsenal masivo de defensas!



















Nuestro compañero de IA está específicamente adaptado a las necesidades de los estudiantes. Basándonos en los millones de contenidos que tenemos en la plataforma, podemos dar a los estudiantes respuestas realmente significativas y relevantes. Pero no se trata solo de respuestas, el compañero también guía a los estudiantes a través de sus retos de aprendizaje diarios, con planes de aprendizaje personalizados, cuestionarios o contenidos en el chat y una personalización del 100% basada en las habilidades y el desarrollo de los estudiantes.
Puedes descargar la app en Google Play Store y Apple App Store.
¡Sí lo es! Tienes acceso totalmente gratuito a todo el contenido de la app, puedes chatear con otros alumnos y recibir ayuda inmeditamente. Puedes ganar dinero utilizando la aplicación, que te permitirá acceder a determinadas funciones.
App Store
Google Play
La app es muy fácil de usar y está muy bien diseñada. Hasta ahora he encontrado todo lo que estaba buscando y he podido aprender mucho de las presentaciones. Definitivamente utilizaré la aplicación para un examen de clase. Y, por supuesto, también me sirve mucho de inspiración.
Pablo
usuario de iOS
Esta app es realmente genial. Hay tantos apuntes de clase y ayuda [...]. Tengo problemas con matemáticas, por ejemplo, y la aplicación tiene muchas opciones de ayuda. Gracias a Knowunity, he mejorado en mates. Se la recomiendo a todo el mundo.
Elena
usuaria de Android
Vaya, estoy realmente sorprendida. Acabo de probar la app porque la he visto anunciada muchas veces y me he quedado absolutamente alucinada. Esta app es LA AYUDA que quieres para el insti y, sobre todo, ofrece muchísimas cosas, como ejercicios y hojas informativas, que a mí personalmente me han sido MUY útiles.
Ana
usuaria de iOS
Una increíble aplicación, de verdad. Apareció en el momento en que necesitaba una app que me ayude a organizar mis estudios, al igual que para prepararme para los exámenes. Te da una increíble variedad de estudio que simplemente me encanta. Además de ser una gran ayuda para estudiantes de diferentes grados, como la universidad, lo que más me gusta de esta app es que está para diferentes países.
Bárbara
Chile
Me encantó. La app es superior, buena para los estudiantes. No solo te da las respuestas, sino que también te las explica de una manera asombrosa, lo que hace que entiendas súper rápido. La recomiendo mucho si se te hace difícil comprender las materias que te dejan.
Jennifer
Perú
Muy buena aplicación, da información precisa de lo que se le pide. Es eficiente y, sobre todo, tiene varios intereses a escoger, como por ejemplo, temas sobre el ICFES, temas de bachillerato, entre otros. Excelente app.
Lady
Colombia
¡La app es buenísima! Sólo tengo que introducir el tema en la barra de búsqueda y recibo la respuesta muy rápido. No tengo que ver 10 vídeos de YouTube para entender algo, así que me ahorro tiempo. ¡Muy recomendable!
Sara
usuaria de Android
En el instituto era muy malo en matemáticas, pero gracias a la app, ahora saco mejores notas. Os agradezco mucho que hayáis creado la aplicación.
Roberto
usuario de Android
Me costaba demasiado estudiar porque no entiendo cuando me pongo a estudiar, y en los exámenes me iba mal, hasta que me empezaron a aparecer anuncios y la descargué sin tenerle fe. Gracias a esta aplicación, algo que no entendía hace meses y semanas lo entendí. En esta aplicación mis notas mejoraron, y ya no me tengo que preocupar por estudiar.
Antonella
Argentina
¡Excelente! Amé la app. Me parece súper eficiente. Aparte de que enseña mucho, te ayuda en tus problemas personales y te hace resúmenes. Amo. Amé un montón la app. Sirve para cualquier año, desde sexto hasta quinto año. Aparte, hay resúmenes de otras personas. ¡Nonono, loquísimo! Te la recomiendo al 100%. Efectivamente, es un 10/10.
Usuario argentino
iOS.
Excelente experiencia. La aplicación es buenísima, la recomiendo mucho. Es mucho mejor que ChatGPT. Te manda la respuesta de tus búsquedas y, aparte, diapositivas para estudiar. Es magnífica.
Alo
México
¡ME ENCANTA! Todo es muy sencillo de utilizar y aprender. Mi IA es muy buena y los apuntes de los demás estudiantes son súper buenos; explica las cosas súper bien y detalladamente. La amo. Pruébenla.
Kitty
Colombia
La app es muy fácil de usar y está muy bien diseñada. Hasta ahora he encontrado todo lo que estaba buscando y he podido aprender mucho de las presentaciones. Definitivamente utilizaré la aplicación para un examen de clase. Y, por supuesto, también me sirve mucho de inspiración.
Pablo
usuario de iOS
Esta app es realmente genial. Hay tantos apuntes de clase y ayuda [...]. Tengo problemas con matemáticas, por ejemplo, y la aplicación tiene muchas opciones de ayuda. Gracias a Knowunity, he mejorado en mates. Se la recomiendo a todo el mundo.
Elena
usuaria de Android
Vaya, estoy realmente sorprendida. Acabo de probar la app porque la he visto anunciada muchas veces y me he quedado absolutamente alucinada. Esta app es LA AYUDA que quieres para el insti y, sobre todo, ofrece muchísimas cosas, como ejercicios y hojas informativas, que a mí personalmente me han sido MUY útiles.
Ana
usuaria de iOS
Una increíble aplicación, de verdad. Apareció en el momento en que necesitaba una app que me ayude a organizar mis estudios, al igual que para prepararme para los exámenes. Te da una increíble variedad de estudio que simplemente me encanta. Además de ser una gran ayuda para estudiantes de diferentes grados, como la universidad, lo que más me gusta de esta app es que está para diferentes países.
Bárbara
Chile
Me encantó. La app es superior, buena para los estudiantes. No solo te da las respuestas, sino que también te las explica de una manera asombrosa, lo que hace que entiendas súper rápido. La recomiendo mucho si se te hace difícil comprender las materias que te dejan.
Jennifer
Perú
Muy buena aplicación, da información precisa de lo que se le pide. Es eficiente y, sobre todo, tiene varios intereses a escoger, como por ejemplo, temas sobre el ICFES, temas de bachillerato, entre otros. Excelente app.
Lady
Colombia
¡La app es buenísima! Sólo tengo que introducir el tema en la barra de búsqueda y recibo la respuesta muy rápido. No tengo que ver 10 vídeos de YouTube para entender algo, así que me ahorro tiempo. ¡Muy recomendable!
Sara
usuaria de Android
En el instituto era muy malo en matemáticas, pero gracias a la app, ahora saco mejores notas. Os agradezco mucho que hayáis creado la aplicación.
Roberto
usuario de Android
Me costaba demasiado estudiar porque no entiendo cuando me pongo a estudiar, y en los exámenes me iba mal, hasta que me empezaron a aparecer anuncios y la descargué sin tenerle fe. Gracias a esta aplicación, algo que no entendía hace meses y semanas lo entendí. En esta aplicación mis notas mejoraron, y ya no me tengo que preocupar por estudiar.
Antonella
Argentina
¡Excelente! Amé la app. Me parece súper eficiente. Aparte de que enseña mucho, te ayuda en tus problemas personales y te hace resúmenes. Amo. Amé un montón la app. Sirve para cualquier año, desde sexto hasta quinto año. Aparte, hay resúmenes de otras personas. ¡Nonono, loquísimo! Te la recomiendo al 100%. Efectivamente, es un 10/10.
Usuario argentino
iOS.
Excelente experiencia. La aplicación es buenísima, la recomiendo mucho. Es mucho mejor que ChatGPT. Te manda la respuesta de tus búsquedas y, aparte, diapositivas para estudiar. Es magnífica.
Alo
México
¡ME ENCANTA! Todo es muy sencillo de utilizar y aprender. Mi IA es muy buena y los apuntes de los demás estudiantes son súper buenos; explica las cosas súper bien y detalladamente. La amo. Pruébenla.
Kitty
Colombia
Martín
@zz0mb1t3
El sistema inmunitario es nuestro escudo protector contra gérmenes y enfermedades. Funciona como un ejército organizado que detecta, combate y recuerda a los invasores para defendernos mejor en el futuro. Conocer cómo funciona te ayudará a entender por qué nos... Mostrar más

Acceso a todos los documentos
Mejora tus notas
Únete a millones de estudiantes
¿Alguna vez te has preguntado cómo tu cuerpo lucha contra los resfriados? Todo comienza con los microorganismos, seres diminutos visibles solo con microscopio. Las bacterias son celulares con su propio metabolismo, mientras que los virus son acelulares y necesitan células huésped para reproducirse.
Las bacterias tienen formas variadas como cocos (esferas), bacilos (bastones) y espiroquetas (espirales). ¡Se reproducen súper rápido! En solo 20 minutos pueden duplicarse mediante fisión binaria. Los virus, por su parte, pueden seguir ciclos líticos (reproducción activa) o lisogénicos (permanecen latentes).
Tu sistema inmunitario es un equipo complejo de células, tejidos y órganos que trabajan juntos para protegerte. Sus principales tareas son detectar invasores, eliminarlos, prevenir que vuelvan a infectarte y eliminar células defectuosas como las cancerosas.
¡Dato curioso! Aunque muchos microorganismos pueden causarnos enfermedades, la mayoría son inofensivos e incluso algunos son beneficiosos para nuestra salud, como las bacterias intestinales que nos ayudan a digerir alimentos.

Acceso a todos los documentos
Mejora tus notas
Únete a millones de estudiantes
Tu cuerpo es muy inteligente para identificar intrusos. El sistema inmunitario detecta antígenos (moléculas extrañas) en la superficie de bacterias y virus. Cuando encuentra estos antígenos, produce anticuerpos específicos para combatirlos.
Imagina que una bacteria intenta invadir tu cuerpo. Tu sistema inmunitario identifica proteínas en su membrana como "extrañas". De forma similar, cuando un virus como el coronavirus intenta infectarte, las proteínas de su superficie (como las proteínas S, E y M) son reconocidas como invasoras.
Es como si cada intruso llevara una etiqueta que dice "¡No pertenezco aquí!" y tu sistema inmunitario está constantemente vigilando para detectar estas etiquetas.
¡Importante! La especificidad es la clave del sistema inmunitario: los anticuerpos se ajustan exactamente al antígeno como una llave a su cerradura. Esta precisión permite atacar solo a los invasores sin dañar tus propias células.

Acceso a todos los documentos
Mejora tus notas
Únete a millones de estudiantes
Tu sistema inmunitario tiene su propia geografía, con órganos especializados distribuidos por todo el cuerpo. Se organiza en dos tipos principales: órganos linfoides primarios (donde las células inmunitarias nacen y maduran) y secundarios (donde actúan).
La médula ósea es la fábrica principal donde se producen todas las células sanguíneas, incluidas las células inmunitarias. El timo es como una escuela donde las células T aprenden a distinguir lo propio de lo extraño. Los ganglios linfáticos, las amígdalas y el bazo funcionan como puestos de control donde se inician las respuestas inmunitarias.
El proceso de selección clonal es fascinante: tu cuerpo genera millones de células con receptores diferentes, elimina las que podrían atacar tus propias células, y cuando encuentra un invasor, selecciona y multiplica las células específicas para combatirlo.
¡Increíble! Tu médula ósea produce unos 100 mil millones de células inmunitarias nuevas cada día. ¡Es como si toda la población de México se renovara diariamente dentro de tu cuerpo!

Acceso a todos los documentos
Mejora tus notas
Únete a millones de estudiantes
Tu cuerpo tiene dos equipos de defensa: la inmunidad innata (rápida pero general) y la inmunidad adaptativa (lenta pero específica y con memoria).
La inmunidad innata es como los guardias de seguridad de un edificio. Responde inmediatamente y de la misma manera ante cualquier intruso. Incluye:
La inmunidad adaptativa es como un equipo de investigadores especializados. Tarda días en activarse pero genera una respuesta específica y mejora con cada exposición. Sus componentes principales son:
¡Dato importante! La inmunidad adaptativa es la razón por la que las vacunas funcionan y por qué generalmente no te da la misma enfermedad dos veces con la misma intensidad.

Acceso a todos los documentos
Mejora tus notas
Únete a millones de estudiantes
¿Te has preguntado por qué algunas enfermedades solo las sufres una vez? La respuesta está en cómo tu sistema inmunitario aprende y recuerda.
La primera vez que te expones a un microbio (respuesta primaria), tu cuerpo tarda entre 10 y 20 días en desarrollar una defensa completa. Es como aprender a jugar un nuevo videojuego: al principio eres lento y cometes errores.
Pero lo interesante ocurre en la segunda exposición (respuesta secundaria). Tu cuerpo reacciona mucho más rápido y con mayor fuerza gracias a las células de memoria que guardaron información del primer encuentro. Es como volver a jugar ese videojuego después de haberlo practicado: ahora eres un experto.
El gráfico de respuesta inmunitaria muestra claramente cómo la segunda vez la reacción es más rápida y potente que la primera, ¡tu cuerpo se vuelve un profesional combatiendo ese invasor específico!
¡Asombroso! Las células de memoria pueden vivir durante décadas, proporcionándote protección a largo plazo contra patógenos que ya has enfrentado antes.

Acceso a todos los documentos
Mejora tus notas
Únete a millones de estudiantes
Tu primera línea de defensa son las barreras físicas y químicas que impiden la entrada de invasores. ¡Es como tener un muro alrededor de tu castillo!
La piel es una increíble fortaleza: sus células apretadas bloquean la entrada de microbios, mientras que el sudor y el sebo contienen sustancias antimicrobianas como la psoriasina que mata bacterias como E. coli. Por eso los médicos insisten tanto en lavarse las manos: ¡para eliminar los invasores antes de que encuentren una entrada!
Las membranas mucosas recubren las aberturas de tu cuerpo como la nariz, boca y tracto digestivo. Producen moco que atrapa microbios, tienen cilios (pequeños pelitos) que los barren hacia afuera, y contienen enzimas que los destruyen. ¡Tu estómago incluso usa ácido para disolver invasores!
¡Experimento real! Científicos demostraron el poder de la psoriasina en nuestra piel poniendo E. coli y S. aureus en dedos humanos. Mientras S. aureus sobrevivió y creció en placas de cultivo, E. coli fue eliminada por la psoriasina. ¡Tu piel tiene su propio antibiótico natural!

Acceso a todos los documentos
Mejora tus notas
Únete a millones de estudiantes
Si algún invasor logra atravesar tus barreras primarias, se encontrará con un ejército de células especializadas listas para "comérselo". Este proceso se llama fagocitosis y es como tener patrullas policiales recorriendo tu cuerpo.
Los principales tipos de células fagocitarias son:
Estas células usan seudópodos (falsos pies) para rodear al invasor, lo encierran en una burbuja llamada fagosoma, y luego lo destruyen con enzimas digestivas de los lisosomas.
¡Increíble! Un solo neutrófilo puede fagocitar hasta 20 bacterias antes de morir. Con millones de estas células circulando en tu sangre, ¡tienes un ejército impresionante!

Acceso a todos los documentos
Mejora tus notas
Únete a millones de estudiantes
Las células NK (Natural Killer) son los francotiradores de tu sistema inmunitario. No necesitan reconocimiento previo para actuar - atacan células infectadas por virus y células cancerosas de inmediato.
¿Cómo distinguen las células buenas de las malas? Las células sanas muestran proteínas llamadas MHC-I que funcionan como un "carnet de identidad". Si una célula no muestra este carnet (como ocurre con células infectadas o cancerosas), las NK la eliminan mediante la liberación de perforinas y granzimas que provocan su muerte programada.
Cuando hay daño tisular o infección, se desencadena la respuesta inflamatoria. Es una reacción compleja que causa los cuatro signos clásicos de la inflamación:
La inflamación atrae a más células defensoras al sitio y acelera la curación. La fiebre también ayuda, pues el aumento de temperatura dificulta la reproducción de muchas bacterias.
¡Dato útil! Aunque la inflamación puede ser molesta, es un signo de que tu sistema inmunitario está trabajando. Sin embargo, una inflamación crónica puede ser perjudicial y está relacionada con muchas enfermedades.

Acceso a todos los documentos
Mejora tus notas
Únete a millones de estudiantes
La inmunidad adaptativa es como tener un equipo SWAT entrenado específicamente para cada tipo de invasor. Sus principales agentes son los linfocitos B y T, que se desarrollan en la médula ósea y el timo respectivamente.
Los linfocitos T son cruciales para la inmunidad celular. Hay varios tipos:
El proceso comienza cuando un fagocito presenta fragmentos del patógeno (antígenos) a los linfocitos T. Estos se activan, se multiplican y algunos se convierten en células de memoria. Los T citotóxicos liberan sustancias que destruyen las células infectadas mediante apoptosis (muerte celular programada).
Para que este sistema funcione, es necesaria la cooperación entre distintos tipos de células. Es como una operación militar donde cada unidad tiene su función específica.
¡Fascinante! Los receptores de los linfocitos T son tan diversos que pueden reconocer prácticamente cualquier molécula extraña. Tu cuerpo puede generar hasta 10^18 (un trillón) de receptores diferentes, ¡más que el número de átomos en la Tierra!

Acceso a todos los documentos
Mejora tus notas
Únete a millones de estudiantes
La inmunidad humoral es tu sistema de defensa basado en anticuerpos, unas proteínas especializadas que circulan en fluidos corporales y "marcan" invasores para su destrucción.
Los linfocitos B son los protagonistas de esta historia. Cuando un linfocito B encuentra un antígeno que encaja con su receptor:
Los anticuerpos actúan de varias formas:
¡Dato asombroso! Una sola célula plasmática puede producir más de 2,000 anticuerpos por segundo durante sus 4-5 días de vida. Con millones de estas células trabajando a la vez, ¡tu cuerpo fabrica un arsenal masivo de defensas!

Acceso a todos los documentos
Mejora tus notas
Únete a millones de estudiantes

Acceso a todos los documentos
Mejora tus notas
Únete a millones de estudiantes

Acceso a todos los documentos
Mejora tus notas
Únete a millones de estudiantes

Acceso a todos los documentos
Mejora tus notas
Únete a millones de estudiantes

Acceso a todos los documentos
Mejora tus notas
Únete a millones de estudiantes

Acceso a todos los documentos
Mejora tus notas
Únete a millones de estudiantes

Acceso a todos los documentos
Mejora tus notas
Únete a millones de estudiantes

Acceso a todos los documentos
Mejora tus notas
Únete a millones de estudiantes

Acceso a todos los documentos
Mejora tus notas
Únete a millones de estudiantes

Acceso a todos los documentos
Mejora tus notas
Únete a millones de estudiantes

Acceso a todos los documentos
Mejora tus notas
Únete a millones de estudiantes

Acceso a todos los documentos
Mejora tus notas
Únete a millones de estudiantes

Acceso a todos los documentos
Mejora tus notas
Únete a millones de estudiantes

Acceso a todos los documentos
Mejora tus notas
Únete a millones de estudiantes

Acceso a todos los documentos
Mejora tus notas
Únete a millones de estudiantes

Acceso a todos los documentos
Mejora tus notas
Únete a millones de estudiantes

Acceso a todos los documentos
Mejora tus notas
Únete a millones de estudiantes

Acceso a todos los documentos
Mejora tus notas
Únete a millones de estudiantes
Acceso a todos los documentos
Mejora tus notas
Únete a millones de estudiantes
Nuestro compañero de IA está específicamente adaptado a las necesidades de los estudiantes. Basándonos en los millones de contenidos que tenemos en la plataforma, podemos dar a los estudiantes respuestas realmente significativas y relevantes. Pero no se trata solo de respuestas, el compañero también guía a los estudiantes a través de sus retos de aprendizaje diarios, con planes de aprendizaje personalizados, cuestionarios o contenidos en el chat y una personalización del 100% basada en las habilidades y el desarrollo de los estudiantes.
Puedes descargar la app en Google Play Store y Apple App Store.
¡Sí lo es! Tienes acceso totalmente gratuito a todo el contenido de la app, puedes chatear con otros alumnos y recibir ayuda inmeditamente. Puedes ganar dinero utilizando la aplicación, que te permitirá acceder a determinadas funciones.
3
Herramientas Inteligentes NUEVO
Transforma estos apuntes en: ✓ 50+ Preguntas de Práctica ✓ Fichas de Estudio Interactivas ✓ Prueba Completa de Práctica ✓ Esquemas de Ensayo
App Store
Google Play
La app es muy fácil de usar y está muy bien diseñada. Hasta ahora he encontrado todo lo que estaba buscando y he podido aprender mucho de las presentaciones. Definitivamente utilizaré la aplicación para un examen de clase. Y, por supuesto, también me sirve mucho de inspiración.
Pablo
usuario de iOS
Esta app es realmente genial. Hay tantos apuntes de clase y ayuda [...]. Tengo problemas con matemáticas, por ejemplo, y la aplicación tiene muchas opciones de ayuda. Gracias a Knowunity, he mejorado en mates. Se la recomiendo a todo el mundo.
Elena
usuaria de Android
Vaya, estoy realmente sorprendida. Acabo de probar la app porque la he visto anunciada muchas veces y me he quedado absolutamente alucinada. Esta app es LA AYUDA que quieres para el insti y, sobre todo, ofrece muchísimas cosas, como ejercicios y hojas informativas, que a mí personalmente me han sido MUY útiles.
Ana
usuaria de iOS
Una increíble aplicación, de verdad. Apareció en el momento en que necesitaba una app que me ayude a organizar mis estudios, al igual que para prepararme para los exámenes. Te da una increíble variedad de estudio que simplemente me encanta. Además de ser una gran ayuda para estudiantes de diferentes grados, como la universidad, lo que más me gusta de esta app es que está para diferentes países.
Bárbara
Chile
Me encantó. La app es superior, buena para los estudiantes. No solo te da las respuestas, sino que también te las explica de una manera asombrosa, lo que hace que entiendas súper rápido. La recomiendo mucho si se te hace difícil comprender las materias que te dejan.
Jennifer
Perú
Muy buena aplicación, da información precisa de lo que se le pide. Es eficiente y, sobre todo, tiene varios intereses a escoger, como por ejemplo, temas sobre el ICFES, temas de bachillerato, entre otros. Excelente app.
Lady
Colombia
¡La app es buenísima! Sólo tengo que introducir el tema en la barra de búsqueda y recibo la respuesta muy rápido. No tengo que ver 10 vídeos de YouTube para entender algo, así que me ahorro tiempo. ¡Muy recomendable!
Sara
usuaria de Android
En el instituto era muy malo en matemáticas, pero gracias a la app, ahora saco mejores notas. Os agradezco mucho que hayáis creado la aplicación.
Roberto
usuario de Android
Me costaba demasiado estudiar porque no entiendo cuando me pongo a estudiar, y en los exámenes me iba mal, hasta que me empezaron a aparecer anuncios y la descargué sin tenerle fe. Gracias a esta aplicación, algo que no entendía hace meses y semanas lo entendí. En esta aplicación mis notas mejoraron, y ya no me tengo que preocupar por estudiar.
Antonella
Argentina
¡Excelente! Amé la app. Me parece súper eficiente. Aparte de que enseña mucho, te ayuda en tus problemas personales y te hace resúmenes. Amo. Amé un montón la app. Sirve para cualquier año, desde sexto hasta quinto año. Aparte, hay resúmenes de otras personas. ¡Nonono, loquísimo! Te la recomiendo al 100%. Efectivamente, es un 10/10.
Usuario argentino
iOS.
Excelente experiencia. La aplicación es buenísima, la recomiendo mucho. Es mucho mejor que ChatGPT. Te manda la respuesta de tus búsquedas y, aparte, diapositivas para estudiar. Es magnífica.
Alo
México
¡ME ENCANTA! Todo es muy sencillo de utilizar y aprender. Mi IA es muy buena y los apuntes de los demás estudiantes son súper buenos; explica las cosas súper bien y detalladamente. La amo. Pruébenla.
Kitty
Colombia
La app es muy fácil de usar y está muy bien diseñada. Hasta ahora he encontrado todo lo que estaba buscando y he podido aprender mucho de las presentaciones. Definitivamente utilizaré la aplicación para un examen de clase. Y, por supuesto, también me sirve mucho de inspiración.
Pablo
usuario de iOS
Esta app es realmente genial. Hay tantos apuntes de clase y ayuda [...]. Tengo problemas con matemáticas, por ejemplo, y la aplicación tiene muchas opciones de ayuda. Gracias a Knowunity, he mejorado en mates. Se la recomiendo a todo el mundo.
Elena
usuaria de Android
Vaya, estoy realmente sorprendida. Acabo de probar la app porque la he visto anunciada muchas veces y me he quedado absolutamente alucinada. Esta app es LA AYUDA que quieres para el insti y, sobre todo, ofrece muchísimas cosas, como ejercicios y hojas informativas, que a mí personalmente me han sido MUY útiles.
Ana
usuaria de iOS
Una increíble aplicación, de verdad. Apareció en el momento en que necesitaba una app que me ayude a organizar mis estudios, al igual que para prepararme para los exámenes. Te da una increíble variedad de estudio que simplemente me encanta. Además de ser una gran ayuda para estudiantes de diferentes grados, como la universidad, lo que más me gusta de esta app es que está para diferentes países.
Bárbara
Chile
Me encantó. La app es superior, buena para los estudiantes. No solo te da las respuestas, sino que también te las explica de una manera asombrosa, lo que hace que entiendas súper rápido. La recomiendo mucho si se te hace difícil comprender las materias que te dejan.
Jennifer
Perú
Muy buena aplicación, da información precisa de lo que se le pide. Es eficiente y, sobre todo, tiene varios intereses a escoger, como por ejemplo, temas sobre el ICFES, temas de bachillerato, entre otros. Excelente app.
Lady
Colombia
¡La app es buenísima! Sólo tengo que introducir el tema en la barra de búsqueda y recibo la respuesta muy rápido. No tengo que ver 10 vídeos de YouTube para entender algo, así que me ahorro tiempo. ¡Muy recomendable!
Sara
usuaria de Android
En el instituto era muy malo en matemáticas, pero gracias a la app, ahora saco mejores notas. Os agradezco mucho que hayáis creado la aplicación.
Roberto
usuario de Android
Me costaba demasiado estudiar porque no entiendo cuando me pongo a estudiar, y en los exámenes me iba mal, hasta que me empezaron a aparecer anuncios y la descargué sin tenerle fe. Gracias a esta aplicación, algo que no entendía hace meses y semanas lo entendí. En esta aplicación mis notas mejoraron, y ya no me tengo que preocupar por estudiar.
Antonella
Argentina
¡Excelente! Amé la app. Me parece súper eficiente. Aparte de que enseña mucho, te ayuda en tus problemas personales y te hace resúmenes. Amo. Amé un montón la app. Sirve para cualquier año, desde sexto hasta quinto año. Aparte, hay resúmenes de otras personas. ¡Nonono, loquísimo! Te la recomiendo al 100%. Efectivamente, es un 10/10.
Usuario argentino
iOS.
Excelente experiencia. La aplicación es buenísima, la recomiendo mucho. Es mucho mejor que ChatGPT. Te manda la respuesta de tus búsquedas y, aparte, diapositivas para estudiar. Es magnífica.
Alo
México
¡ME ENCANTA! Todo es muy sencillo de utilizar y aprender. Mi IA es muy buena y los apuntes de los demás estudiantes son súper buenos; explica las cosas súper bien y detalladamente. La amo. Pruébenla.
Kitty
Colombia